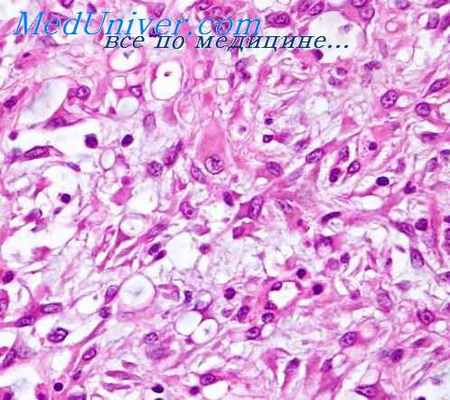
рабдомиосаркома

Рабдомиосаркома. Кожная рабдомиосаркома.
Добавил пользователь Алексей Ф. Обновлено: 06.01.2026
Рабдомиосаркома – опухоль у детей, развивающаяся из эмбриональных мезенхимальных клеток, которые потенциально могут дифференцироваться в клетки скелетных мышц. Она может возникать из практически любого типа мышечной ткани в любом месте, в результате чего клинические проявления сильно варьируются. Опухоль обычно обнаруживают при КТ или МРТ и подтверждают диагноз биопсией. Лечение включает хирургическое удаление, лучевую химиотерапию.
Две трети случаев диагностируют у детей 7 лет. Заболевание чаще встречается у белых, чем у черных (в значительной степени из-за того, что частота ниже у черных девочек), и несколько чаще среди мальчиков, чем среди девочек.
Общие справочные материалы
1. Siegel RL, Miller KD, Fuchs HE, et al: Cancer Statistics, 2021. CA Cancer J Clin 71(1):7–33, 2021. doi: 10.3322/caac.21654
Гистология
Существуют 2 основных гистологических подтипа:
Эмбриональный – характеризуется потерей гетерозиготности на хромосоме 11p15.5
Альвеолярная: связана с транслокацией t(2; 13), который соединяет ген PAX3 с геном FOXO1 (FKHR), и t(1; 13), который соединяет ген PAX7 с геном FOXO1 (FKHR)
Расположение
Хотя рабдомиосаркома может возникнуть практически в любом месте в организме, но рак преимущественно локализуется в нескольких местах:
в области головы и шеи (порядка 35%), как правило, на орбите или носоглоточных отверстиях: наиболее распространена среди детей школьного возраста;
в мочеполовой системе (около 25%), обычно в мочевом пузыре, предстательной железе или влагалище: как правило, возникает у младенцев и детей младшего возраста;
на конечностях (около 20%): наиболее распространенная форма среди подростков
Корпусные/смешанные локализации (около 20%)
Метастатический процесс развивается примерно у 15–25% детей. Легкое является наиболее распространенным местом метастазов; кости, костный мозг, лимфатические узлы - другие возможные места расположения.
Симптомы и признаки рабдомиосаркомы
Дети обычно не имеют системных проявлений, таких как лихорадка, ночная потливость или потеря веса. Как правило, у детей выявляют пальпируемое образование или дисфункцию органов из-за воздействия на них опухолей.
Орбитальные и носоглоточные опухоли могут вызвать слезотечение, боль в глазах или экзофтальм. Опухоль носоглоточной полости может вызывать заложенность носа, изменение голоса или слизисто-гнойные выделения.
Опухоли мочеполовой системы являются причиной болей в животе, пальпируемых образований в брюшной полости, затруднения мочеиспускания и гематурии.
РМС конечностей проявляется как однородное образование в любом месте на руках или ногах. Распространение по региональным лимфатическим узлам случается часто, и метастазы могут возникать в легких, костном мозге и лимфатических узлах, и они обычно не вызывают симптомов.
Диагностика рабдомиосаркомы
Образования оценивают с помощью КТ, хотя повреждения головы и шеи часто лучше выявлять с помощью МРТ. Диагноз рабдомиосаркомы подтверждают с помощью биопсии или резекции образования.
Стандартная оценка на метастазы включает КТ грудной клетки, позитронно-эмиссионную компьютерную томографию (ПЭТ-КТ), сканирование костей, билатеральную аспирацию костного мозга и биопсию.
Прогноз при рабдомиосаркоме
Локализация опухоли (например, прогноз лучше при непараменингеальных злокачественных опухолях головы/шеи и злокачественных опухолях мочеполовой системы, не связанных с мочевым пузырем/простатой)
На наличии метастазов
Возраст (прогноз хуже для детей возрастом 10 лет
На гистологии (эмбриональная РМС ассоциирована с лучшим результатом, чем альвеолярная)
Комбинации этих прогностических факторов распределяют пациентов в категории низкого, среднего или высокого риска. Существует сложная система стратификации риска (смотри stage information for rhabdomyosarcoma Национальных институтов рака). Лечение зависит от группы риска, и общая выживаемость варьируется от > 90% у детей с низким риском до 50% у детей с высоким риском.
Лечение рабдомиосаркомы
Хирургическое удаление и химиотерапия
Лучевая терапия при остаточных или микроскопических образованиях
Лечение злокачественной рабдомиомы состоит в хирургическом удалении, химиотерапии, а иногда и лучевой терапии.
Рекомендуется полное иссечение первичного очага, если это можно сделать безопасно. Поскольку рак высокочувствительн к химиотерапии и лучевой терапии, от агрессивной резекции лучше отказаться, если она может привести к повреждению и дисфункции органов.
Детей всех категорий риска лечат с использованием химиотерапии, наиболее часто используемые препараты – винкристин, актиномицин D (дактиномицин), циклофосфамид, доксорубицин, ифосфамид и этопозид. Топотекан и иринотекан - более новые препараты, обладающие активностью против этого вида рака.
Лучевая терапия, как правило, предназначается для детей с остаточной массивной лимфаденопатией или микроскопической остаточной опухолью, которым были выполнены операции, и для детей с заболеванием промежуточной или высокой степени риска.
Дополнительная информация
Ниже следует англоязычный ресурс, который может быть информативным. Обратите внимание, что The manual не несет ответственности за содержание этого ресурса.
Авторское право © 2022 Merck & Co., Inc., Rahway, NJ, США и ее аффилированные лица. Все права сохранены.
Рабдомиосаркома
Рабдомиосаркома — один из вариантов злокачественных новообразований мягких тканей (сарком). Она диагностируется у людей любого возраста, но чаще выявляется у детей дошкольного и раннего школьного возраста. Чаще всего единственным симптомом заболевания является наличие безболезненной опухоли, которая ошибочно расценивается как доброкачественное новообразование. Без своевременного лечения прогноз крайне неблагоприятный — рабдомиосаркомы быстро прогрессируют и дают метастазы.
Общая информация
Саркомы мягких тканей — редкие заболевания в онкологии. Под мягкими понимают все ткани организма, которые развиваются из зародышевой мезенхимы и нейроэктодермы: гладкую и поперечно-полосатую мускулатуру, сосуды, связки и сухожильный аппарат, хрящевую и жировую ткани, а также периферические нервы. Саркомы объединяют в себе около 30 различных морфологических вариантов опухолей и составляют всего лишь 1% от всех злокачественных новообразований.
Рабдомиосаркома — злокачественное новообразование, развивающееся из клеток-предшественниц поперечно-полосатой (скелетной) мускулатуры. В детской онкологии она рассматривается как одно из самых злокачественных новообразований с неблагоприятным прогнозом. Рабдомиосаркома составляет около 4% от всех опухолей у детей, при этом 60-70% клинических случаев приходится на возраст до 10 лет. Значительно реже встречается заболевание у подростков и взрослых лиц.
Причины и механизм развития
Точные причины появления рабдомиосаркомы остаются неизвестными. По мнению ряда авторов, ведущий фактор в развитии заболевания — наследственная предрасположенность. К второстепенным причинам появления злокачественного новообразования относят:
- влияние радиационного излучения;
- воздействие химических, пищевых и промышленных канцерогенов;
- врожденные и приобретенные иммунодефицитные состояния;
- травмы мягких тканей;
- наличие вредных привычек, пассивное курение.
Под влиянием одного или нескольких перечисленных факторов происходят клеточные мутации, которые не поддаются контролю иммунной системы организма. На начальных стадиях рабдомиосаркома представляет собой микроскопический узел, состоящий из атипичных (видоизмененных) клеток. В дальнейшем происходит их бесконтрольное деление, что и приводит к увеличению злокачественного новообразования.
Большая часть гистологически подтвержденных рабдомиосарком имеет крайне быстрый рост и агрессивное течение с инвазией в окружающие здоровые ткани. С морфологической точки зрения проблема злокачественных новообразований заключается в отсутствии у них капсулы, отграничивающей опухоль. Хоть рабдомиосаркома и имеет четкие контуры, но прогрессирование заболевания и разрастание опухоли всегда сопровождается инвазией и инфильтрацией окружающих здоровых тканей. Рост опухолевого узла происходит несколькими путями: в толщу поперечно-полосатой мускулатуры, по межмышечным пространствам, а также вдоль фасций (мышечные футляры), нервов или сосудов.
В клинической практике выделяют три типа рабдомиосарком: эмбриональная, альвеолярная и плеоморфная. Эмбриональный тип опухоли встречается чаще остальных и, как правило, диагностируется у младенцев и детей до 3-5 лет. Типичная локализация такой рабдомиосаркомы — область головы и шеи, мочевой пузырь, влагалище, предстательная железа и яички.
Альвеолярная опухоль встречается у подростков и взрослых. Обычно она располагается в области крупных мышц туловища и конечностей (чаще на бедре или голени). Плеоморфная рабдомиосаркома может расти на любой части тела, но чаще всего появляется на нижних конечностях. Диагностируется этот тип злокачественного новообразования преимущественно у взрослых.
Классификации
Существует несколько классификаций рабдомиосарком. Наиболее полную информацию о характере и распространенности процесса имеет международная ТNM-классификация:
Т — описание первичной опухоли
- Тх — недостаточно данных для оценки злокачественного новообразования
- Т1 — опухоль не более 5 см в любом из измерений; Т1а — расположена поверхностно, Т1b — находится глубоко в толще здоровых тканей;
- Т2 — рабдомиосаркома более 5 см в наибольшем измерении; подгруппы Т2а и Т2b имеют схожие критерии;
N — регионарные (расположенные вблизи от опухоли) лимфоузлы
- Nx — недостаточно лабораторно-инструментальных данных для оценки поражения лимфатических узлов;
- N0 — нет метастазов в регионарных лимфоузлах;
- N1 — есть признаки метастазирования в один или более лимфатический узел;
M — отдаленные метастазы в другие системы органов
- Mx — нет данных об отдаленном метастазировании;
- M0 — отдаленный метастатический процесс отсутствует;
- M1 — выявлены отдаленные метастазы.
Еще одна классификация рабдомиосарком — клиническая. Она учитывает степень распространенности злокачественного новообразования и возможность хирургического лечения. Клиническая классификация подразделяет всех пациентов с рабдомиосаркомами на 4 группы:
- 1 группа — злокачественный процесс полностью локализован, регионарные или отдаленные метастазы отсутствуют, опухоль поддается хирургическому иссечению;
- 2 группа — рабдомиосаркома имеет локализованный рост, но не подлежит полному удалению по результатам гистологического исследования (по краю иссечения опухоли имеются атипичные клетки), имеются метастазы в регионарных лимфатических узлах;
- 3 группа — полное удаление опухоли невозможно, что определяется невооруженным глазом (например, врастание в крупные сосуды и нервы), признаки отдаленного метастазирования отсутствуют;
- 4 группа — хирургическое лечение невозможно или не принесет положительного результата, имеются отдаленные метастазы.
В зависимости от степени дифференцировки и зрелости клеток, составляющих опухоль, выделяют два типа рабдомиосарком: высоко- и низкодифференцированные. Первый тип опухолей, как правило, имеет более благоприятный прогноз. В то же время, рабдомиосаркомы с низкой степенью дифференцировки отличаются крайне агрессивным течением и быстро дают метастазы в регионарные лимфатические узлы и другие органы.
Оценка злокачественности проводится врачом-патоморфологом во время гистологического исследования по специальной классификации Grade. Она отражает степень визуальной схожести опухоли с нормальной поперечно-полосатой мускулатурой. Чем меньше клетки злокачественного новообразования похожи на мышечные, тем ниже дифференцировка и выше злокачественность рабдомиосаркомы. Высокодифференцированными считаются опухоли Grade 1, все остальные относятся к саркомам средней или низкой степени зрелости.
Важное клиническое значение имеет разделение рабдомиосарком области головы и шеи на две группы: параменингеальные и непараменингеальные. К первому типу относятся злокачественные опухоли, локализованные в полости носа, уха или носоглотки, а также в крылонебной или подвисочной ямке, ко второму типу — все остальные.

Симптомы
Клинические проявления рабдомиосаркомы зависят от нескольких факторов:
- локализация опухоли;
- размеры и степень распространенности процессов;
- возраст пациента.
На ранних стадиях заболевание не имеет каких-либо признаков. Характерные клинические симптомы появляются при росте рабдомиосаркомы, когда ее можно обнаружить невооруженным глазом или она начинает сдавливать окружающие здоровые ткани.
Наиболее частой причиной обращения за медицинской помощью становится появление одиночной безболезненной опухоли на теле. Типичная локализация рабдомиосаркомы — лицо и шея, передняя и задняя поверхность бедра, область икроножных мышц, верхняя и средняя треть руки. Примерно у 2/3 пациентов факт наличия прощупываемой опухоли является первым и единственным симптомом заболевания.
При внимательном ощупывании можно определить следующие признаки злокачественного новообразования:
- округлая или овальная форма;
- упруго- или плотноэластическая консистенция;
- ровная поверхность;
- четкие контуры;
- несмещаемость;
- безболезненность при пальпации (прощупывании).
При поверхностной локализации рабдомиосаркомы в мышцах конечности возможно небольшое ее смещение под пальцами в поперечном направлении в обе стороны. При сокращении мускулатуры опухоль становится полностью неподвижной. В случае межмышечного расположения злокачественного новообразования ощупывание возможно только при полном расслаблении конечности, при сокращении мышц рабдомиосаркома теряет свои очертания.
На начальных стадиях кожа над пораженной областью не изменена. В дальнейшем появляется местное повышение температуры, незначительное покраснение и отечность. С ростом рабдомиосаркомы кожа над ней истончается, приобретает восковой блеск и имеет выраженный сосудистый рисунок. На поздних стадиях она может приобретать багрово-синюшный оттенок. При прорастании злокачественного новообразования в подкожно-жировую клетчатку и кожу или распаде опухоли может наблюдаться изъязвление кожных покровов, кровоточивость, незаживляемость ран.
При прогрессировании заболевания у части пациентов также появляются жалобы на боль или нарушение функции пораженной части тела. Это связано со сдавлением или врастанием в сосудисто-нервные пучки, прорастанием в капсулу сустава или надкостницу.
В случае локализации опухоли в области ЛОР-органов могут появиться неспецифические симптомы в виде заложенности в ушах, затруднения носового дыхания, необильных носовых кровотечений и других. Часто поражение ЛОР-органов расценивается как инфекционное или аллергическое заболевание, что приводит к позднему выявлению злокачественного процесса.
На поздних стадиях рабдомиосаркомы появляются симптомы раковой интоксикации. Они обусловлены ростом опухоли, метастазированием в органы и попаданием продуктов ее распада в кровь. Среди клинических проявлений раковой интоксикации — снижение веса вплоть до истощения, слабость, потеря аппетита, расстройство работы желудочно-кишечного тракта, анемия.
Диагностика
Первый этап обследования — сбор жалоб, анамнеза и физикальный осмотр пациента. Важное клиническое значение имеют данные о давности обнаружения опухоли пациентом и темпе ее роста. Если скорость роста рабдомиосаркомы увеличилась, обязательно уточняют предрасполагающие факторы (травма, пункция или биопсия новообразования). После опроса врач ощупывает новообразование и мягкие ткани вокруг него, а также регионарные лимфатические узлы.
Для визуализации опухоли используются следующие методы инструментальной диагностики:
- рентгенография — прицельные «мягкие» рентгенограммы позволяют определить тень опухоли, гомогенность (однородность) и характер контуров новообразования;
- УЗ-исследование мягких тканей — простой и доступный метод выявления как первичного очага и его характера, так и метастатического поражения лимфатических узлов;
- рентгеновская компьютерная томография — метод дает возможность получить четкое изображение не только злокачественного новообразования, но и оценить его взаимоотношение с окружающими тканями;
- магнитно-резонансная томография — исследование помогает получить наиболее четкую картину мягких тканей и сосудисто-нервных пучков в зоне поражения.
Обязательным является гистологическое подтверждение диагноза. Для этого могут использоваться различные методы забора материала: пункция опухоли для цитологического исследования, прицельная трепанбиопсия под УЗИ-контролем, ножевая биопсия. Наименьшей информативностью среди них обладает простая пункция, т.к. цитологический метод не во всех случаях позволяет определить злокачественную природу и степень дифференцировки опухолевого образования.
Для выявления отдаленных метастазов используются методы УЗИ-диагностики (органы брюшной полости и забрюшинного пространства, лимфоузлы), рентгенографии (органы грудной клетки, кости скелета) и томографии (органы грудной и брюшной полости, костная система).

Лечение
Выбор терапевтической тактики подбирают индивидуально. Врачом учитывается множество факторов, в первую очередь, возраст пациента, гистологический тип, локализация и размеры злокачественного новообразования, а также стадия онкологического процесса.
Для лечения рабдомиосарком используются следующие методы:
- хирургический — иссечение злокачественного новообразования;
- химиотерапия — курсы препаратов, обладающих цитостатическим действием;
- лучевая терапия — облучение как самой опухоли, так и очагов метастатического поражения;
- комбинированный — использование нескольких методов терапии.
Несмотря на постоянное совершенствование методик лучевой и химиотерапии, хирургическое вмешательство занимает ведущую роль в тактике лечения. Единственная причина отказа в операции — выявление рабдомиосаркомы в запущенной стадии, когда имеются отдалённые метастазы. Однако даже в этом случае могут проводиться паллиативные (вспомогательные) операции, например, при больших размерах опухоли, значительно нарушающей повседневную активность пациента.
Хирургические вмешательства также не применяются при рабдомиосаркомах параменингеальной локализации из-за высокого риска повреждения жизненно-важных анатомических структур. Во всех остальных случаях операция является основным способом лечения.
Цель хирургического вмешательства заключается в широком иссечении злокачественного новообразования или «блочной» резекции. Обязательным условием является соблюдение принципа футлярности — опухоль, растущая в пределах мышечно-фасциального ложа, должна быть удалена вместе с мышцей и фасцией, ее покрывающей. Там, где из-за анатомических особенностей нельзя соблюсти этот принцип, оптимальным считается отступление не менее, чем на 5 см от края опухоли. Это связано с тем, что на небольшом удалении от основного очага в условно «здоровых тканях» могут находиться микроскопические узелки злокачественных клеток. Если их не удалить, то риск рецидива существенно увеличится.
Химиотерапия может выступать как самостоятельный метод лечения, так и входить в состав комплексной терапии. В комбинации с лучевой терапией она применяется у детей и взрослых с рабдомиосаркомами параменингеальной локализации.
Неоадъювантная (предоперационная) химиотерапия назначается пациентам с большими рабдомиосаркомами для уменьшения их размеров и снижения риска послеоперационного рецидивирования.
Адъювантная (послеоперационная) химиотерапия не является обязательной и не проводится пациентам с местно-распространенным процессом и неблагоприятным прогнозом после хирургического вмешательства. Она используется для стабилизации онкологического процесса и уменьшения размеров опухоли, не поддающейся полному иссечению. Возможность проведения адъювантной химиотерапии обычно рассматривается у пациентов молодого возраста с поверхностно или глубоко расположенными опухолями больших размеров, которые по данным гистологического исследования имеют высокую степень злокачественности.
Осложнения и прогноз
Прогноз заболевания во многом зависит от типа и размеров рабдомиосаркомы, своевременности обращения за медицинской помощью и объема лечения. Злокачественное новообразование характеризуется агрессивным деструктивным ростом, а также быстрым регионарным и отдаленным метастазированием по лимфатическим или кровеносным сосудам.
При раннем выявлении заболевания и комплексном лечении прогноз благоприятный — у 75-80% пациентов удается добиться полного излечения или пятилетней ремиссии. При больших размерах рабдомиосаркомы нередко приходится прибегать к тяжелым инвалидизирующим операциям. Однако, даже после комплексного лечения риск рецидива заболевания остается высоким.
При обнаружении отдаленных метастазов прогноз неблагоприятный. В таких случаях проводится симптоматическое лечение, направленное на улучшение качества жизни.
В «Евроонко» лечением такого тяжелого заболевания, как рабдомиосаркома занимаются опытные специалисты. Благодаря мощной материально-технической базе клиники и наличию квалифицированного персонала, нам удается достигать хороших результатов даже в самых тяжелых случаях.
Рабдомиосаркома. Кожная рабдомиосаркома.
Рабдомиосаркома. Кожная рабдомиосаркома.
Рабдомиосаркома (син.: злокачественная рабдомиома, миосаркома, рабдомиобластома) — наиболее частая опухоль мягких тканей у детей и юношей. На ее долю приходится около 19% детских сарком. Может развиваться вне связи с мышечной тканью (в забрюшинной клетчатке, средостении, налице и шее, в носоглотке, по ходу мочеполового тракта, в женских половых органах), но чаще локализуется в зоне расположения мышц (нижние и верхние конечности, туловище). Кожные рабдомиосаркомы (как первичные, так и метастатические) чрезвычайно редки и также развиваются преимущественно у детей.
Первые случаи рабдомиосаркомы были описаны в начале ХIХ в. Считается что эти опухоли имеют мышечное происхождение, хотя развиваются не из зрелых поперечнополосатых мышц, а скорее всего, из примитивной или недифференцированной мезенхимальной ткани со способностью к рабдопоэтической дифференцировке; это подтверждается случаями возникновения опухоли в органах, в норме не содержащих поперечнополосатые мышцы — например в мочевом пузыре. Альтернативная теория предполагает возможность развития опухоли из перемещенных эмбриональных мышц на ранней стадии развития тканей.
Этиология рабдомиосаркомы изучена недостаточно. О роли в ее развитии генетических факторов свидетельствуют нередкие случаи наличия опухоли с рождения, возникновение ее у сибсов, ассоциация опухоли с синдромом Ли Фра-умени, связанного с мутациями опухоль супрессорного гена р53. Также описаны случаи сочетания рабдомиосаркомы с врожденной ретинобластомой, нейрофиброматозом, семейным полипозом, гигантским врожденным меланоцитарным невусом, эпидермальными невусами, синдромом Горлина—Гольтца, синдромом множественного лентиго и альбинизмом.
Средний возраст больных рабдомиосаркомой составляет 9,9 года, а средний возраст больных детей — 4,3 года Отмечается некоторое преобладание среди пациентов лиц мужского пола, соотношение мужчин и женщин примерно 1,3:1.
Гистологическое строение рабдомиосаркомы
Гистологически выделяют альвеолярную, эмбриональную, плеоморфную, ботриоидную, а также веретеноклеточную разновидности рабдомиосаркомы. В ряде случаев в пределах одной опухоли могут отмечаться несколько разновидностей рабдомиосаркомы (смешанные формы).
Альвеолярная рабдомиосаркома составляет около 60% всех кожных рабдомиосарком. Микроскопически она образована скоплениями недифференцированных, преимущественно округлых или овальных опухолевых клеток с четко очерченной цитоплазмой и дольчатым или почковидным ядром. Наиболее важным признаком этой разновидности является альвеолярный характер строения, создаваемый за счет большого числа гиалинизированных фиброзных перегородок. Наблюдается также большое количество беспорядочно расположенных сосудов, встречаются многоядерные гигантские клетки.
Эмбриональная рабдомиосаркома составляет до 1/3 кожных рабдомиосарком. Как указывает название, по гистологическому строению эта опухоль напоминает эмбриональную стадию нормальной поперечнополосатой мышцы. Она образована преимущественно мелкими клетками разнообразной формы — от круглых до звездчатых или тонких вытянутых, биполярных, формирующих переплетающиеся пучки или массу типа синовильной. Клетки располагаются в миксоматозном основном веществе. Важное диагностическое значение имеют вытянутые клетки (лентообразные, полосовидные) с эозинофильной цитоплазмой, имеющие иногда поперечную исчерченность в цитоплазме. Веретеноклеточный вариант включен в эту же разновидность в связи с хорошим клиническим исходом.
Плеоморфная рабдомиосаркома встречается реже других вариантов. Она образована вытянутыми клетками с выраженной эозинофильной цитоплазмой и полиморфизмом клеточных форм. Характерными являются полосовидные, ракеткообразные и паукообразные клетки. Для установления диагноза часто требуются иммуногистохимическое исследование и электронная микроскопия.
Ботриоидная рабдомиосаркома характеризуется наличием так называемого камбиального пласта: разнонаправленных пучков и скоплений компактно расположенных опухолевых клеток непосредственно под эпителием слизистой оболочки. В остальном неотличима от эмбриональной рабдомиосаркомы. Случаи кожной ботриоидной рабдомиосаркомы не описаны.
При иммуногистохимическом выявлении рабдомиосарком используют антитела, направленные против десмина, мышечно-специфического актина (HHF-35) и миоглобина, менее чувстительными маркерами являются антитела против виментина, миозина, креатининкиназы. Виментин фактически экспрессируется всеми рабдомиосаркомами, включая кожные опухоли. В некоторых опухолях отмечено положителвное окрашивание на протеин S-100, нейрон-специфическую энолазу и цитокератин.
Электронно-микроскопический материал рабдомиосаркомы напоминает различные стадии развития эмбриональной мышцы. Наиболее достоверным ультраструктурным признаком, указывающим на миогенное происхождение опухоли, является наличие в саркоматозных клетках характерных фибриллярных структур: тонких (актин) и толстых (миозин) миофиламентов. Из структур, образующих поперечную исчерченность, наблюдаются уплотнения, соответствующие Z-дискам, или несколько размытые и менее плотные полосы, напоминающие Z-материал будущих Z-дисков. Z-диски могут ограничивать саркомеры или беспорядочно располагаться в клетке поперек или вдоль миофибрилл. Реже в коротких и длинных пучках миофиламентов выявляются чередующиеся темные и све лые полосы, напоминающие А- и I-диски.
Течение рабдомиосаркомы.
Первичные кожные рабдомиосаркомы дают лимфогенные и гематогенные метастазы. Основными местами метастазирования являются легкие, лимфатические узлы, костный мозг, реже происходит метастазирование в сердце, головной мозг и мозговые оболочки, поджелудочную железу, печень, почки. Мета-стазировавшие опухоли обычно менее дифференцированные. Кожные метастазы редки.
Лечение рабдомиосарком является междисциплинарной проблемой и заключается в хирургическом удалении опухоли (если возможно, экстирпации), полихимиотерапии и лучевой терапии. При этом хирургическое удаление должно предшествовать всем другим методам на любой стадии опухоли.
Наиболее важным прогностическим фактором при рабдомиосаркоме является принадлежность к одной из четырех клинических групп, разработанных международной группой по изучению рабдомиосарком, в зависимости от степени распространения опухоли, объема оперативного вмешательства и наличия метастазов.
I клиническая группа рабдомиосаркомы: процесс локальный, опухоль полностью резектабельна, без поражения регионарных лимфатических узлов.
IA Процесс ограничен мышцей или органом.
IБ. Процесс распространяется на прилежащие ткани или органы, макро- и микроскопическое исследование подтверждает полноту иссечения. II клиническая группа:
IIА. Макроскопическси резектабильная опухоль без клинических или морфологических признаков поражения регионарных лимфатических узлов, но с микроскопически обнаруженными элементами опухоли по линии резекции;
IIБ Вовлечены регионарные лимфатические узлы и отмечается распространение опухолевого процесса на прилежащие ткани и органы; однако вся опухоль полностью резектабельна и микроскопические элементы опухоли по краю резекции не обнаруживаются.
IIВ. Процесс с вовлечением лимфатических узлов, макроскопически резектабельный, но микроскопически обнаруживаются остатки опухоли.
III клиническая группа: неполная резекция или биопсия опухоли, макроскопически обнаруживаются остатки опухоли.
IV клиническая группа: имееется метастатическое поражение.
После операции по поводу рабдомиосаркомы больные I группы получают полихимиотерапию (винкристин, актиномицин); больные II группы — лучевую терапию, а затем полихимиотерапию, включая пульс-терапию циклофосфамидом; больным III и IV групп дополнительно назначают доксурубицин, а лучевую терапию используют также для лечения метастатических очагов.
Прогноз при рабдомиосаркоме зависит не только от распространения и локализации первичной опухоли. Первичные опухоли головы и шеи, исключая орбиту, прогностически неблагоприятны. Альвеолярные и плеоморфные опухоли имеют худший прогноз. У больных I и II групп прогноз наилучший. 5-летняя выживаемость составляет 85-88%. Исключением являются альвеолярные рабдомиосаркомы конечностей. Показатель 5-летней выживаемости у больных III группы снижается до 66%; у больных IV группы до 20%. Общий 5-летний уровень выживания для больных рабдомиосаркомой составляет 63%. Больные редко выживают при развитии во время лечения местного рецидива или метастазов.
Информация на сайте подлежит консультации лечащим врачом и не заменяет очной консультации с ним.
См. подробнее в пользовательском соглашении.
Рабдомиосаркома
Рабдомиосаркома – редкое злокачественное новообразование из незрелой поперечно-полосатой мышечной ткани. Обычно локализуется в скелетных мышцах, но может располагаться и в других мягких тканях: в забрюшинной клетчатке, клетчатке средостения, в носоглотке, на лице, в области желчевыводящих или мочевыводящих путей и т. д. Проявляется деформацией пораженной области и симптомами сдавления близлежащих органов. При отдаленном метастазировании выявляются признаки нарушения функций соответствующих органов. Диагноз выставляется на основании клинических данных, результатов инструментальных и лабораторных исследований. Лечение комплексное: операции, радиотерапия, химиотерапия.
Общие сведения
Рабдомиосаркома – злокачественная опухоль мягких тканей, поражающая преимущественно детей и подростков. Происходит из недифференцированной мезенхимальной ткани-предшественницы поперечно-полосатых мышц. Рабдомиосаркома может локализоваться в скелетных мышцах, клетчатке и гладкомышечной ткани внутренних органов. Расположение в области лица и шеи обусловлено нарушениями внутриутробного развития дериватов жаберных дуг. По различным данным составляет 19-50% от общего количества сарком детского возраста. Средний возраст пациентов – 9,9 лет. Пики заболеваемости рабдомиосаркомой приходятся на возраст 1-7 лет и 15-20 лет. Мальчики страдают чаще девочек. Лечение осуществляют специалисты в области онкологии, травматологии-ортопедии, дерматологии, отоларингологии, гинекологии, гастроэнтерологии, урологии и т. д. (в зависимости от локализации новообразования).
Причины рабдомиосаркомы
Этиология рабдомиосаркомы окончательно не выяснена. Случаи врожденных новообразований, высокая вероятность возникновения у ближайших родственников, сочетание данного заболевания с изолированными пороками развития и различными врожденными синдромами указывают на наследственную предрасположенность. У 30% пациентов рабдомиосаркома сочетается с аномалиями развития центральной нервной системы, половых органов, мочевыводящей системы, пищеварительной системы или сердечно-сосудистой системы.
Описаны случаи сочетания рабдомиосаркомы с семейным диффузным полипозом, врожденной ретинобластомой, эпидермальным невусом, врожденным меланоцитным невусом, альбинизмом и синдромом множественного лентиго. Рабдомиосаркома может возникать при синдроме Ли-Фраумени, характеризующемся склонностью к развитию злокачественных опухолей, а также при синдроме Реклингхаузена (нейрофиброматозе I типа, нейрофиброматозе с феохромоцитомой) и синдроме Рубинштейна-Тейби, при котором выявляются олигофрения, нарушения прикуса, клювовидный нос, асимметрия лица, астигматизм, карликовость, различные скелетные аномалии и пороки развития внутренних органов.
Классификация рабдомиосаркомы
С учетом особенностей гистологического строения выделяют следующие разновидности рабдомиосаркомы: альвеолярная, эмбриональная, плеоморфная, ботриоидная.
- Альвеолярная. Составляет 9% от общего числа рабдомиосарком и 60% от общего количества кожных поражений. Представлена овальными или круглыми недифференцированными клетками с почковидным либо дольчатым ядром, напоминающими клетки поперечно-полосатых мышц 10-20 недельного плода. Образуют скопления, разделенные фиброзными перегородками, что придает рабдомиосаркоме сходство с альвеолярной тканью. Опухоль чаще возникает в области туловища или конечностей. Обычно страдают больные в возрасте от 5 до 20 лет.
- Эмбриональная. Составляет 57% от общего числа рабдомиосарком и 30% от общего количества кожных поражений. Представлена клетками различной формы: вытянутыми, круглыми, звездчатыми и т. д., расположенными в миксоматозном веществе. Напоминает поперечно-полосатые мышцы 7-10 недельного плода. Чаще локализуется в области орбиты, шеи, головы и мочеполового тракта. Обычно диагностируется у детей 3-12 лет. К этому типу также относят веретеноклеточный вариант рабдомиосаркомы, сходный по прогнозу и клиническому течению.
- Плеоморфная. Составляет около 1% от общего количества рабдомиосарком. Представлена вытянутыми клетками паукообразной, ракеткообразной и полосовидной формы. Не похожа на поперечно-полосатую мышечную ткань человека (в том числе – плода). Обычно возникает в области туловища или конечностей.
- Ботриоидная. Составляет 6% от общего числа рабдомиосарком. В кожном варианте не встречается. Представляет собой скопления клеток, расположенных под эпителием слизистых оболочек. В остальном напоминает эмбриональную рабдомиосаркому. Чаще локализуется в области носоглотки, влагалища, мочевого пузыря и других органов, покрытых слизистой оболочкой. Обычно диагностируется у детей до 8 лет.
Различают также четыре клинических группы рабдомиосаркомы, при этом 1 и 2 группы разделяются на несколько подгрупп:
- 1А – новообразование не выходит за пределы пораженной мышцы или органа.
- 1Б – выявляется поражение близлежащих органов и тканей, данные послеоперационного гистологического исследования материала подтверждают радикальность удаления рабдомиосаркомы.
- 2А – окружающие ткани поражены, лимфатические узлы не задействованы, макроскопически опухоль удалена полностью, при послеоперационном исследовании материала выявляются элементы рабдомиосаркомы по линии удаления.
- 2Б – определяется метастазирование в регионарные лимфоузлы, послеоперационное гистологическое исследование подтверждает полное удаление рабдомиосаркомы.
- 2В – обнаруживается поражение регионарных лимфатических узлов, при послеоперационном исследовании материала по линии удаления видны клетки рабдомиосаркомы.
- 3 группа – опухоль удалена не полностью.
- 4 группа – выявляются метастазы.
Симптомы рабдомиосаркомы
Клинические проявления рабдомиосаркомы определяются ее локализацией, степенью вовлеченности близлежащих органов и наличием или отсутствием отдаленных метастазов. При поверхностном расположении в области скелетных мышц туловища и конечностей, а также на лице и шее определяется плотное, безболезненное опухолевидное образование. Рабдомиосаркомы на руках и ногах могут вызывать нарушение функции конечности. Опухоли в клетчатке забрюшинного пространства в процессе роста могут провоцировать сдавление органов брюшной полости, становясь причиной болей и нарушений деятельности ЖКТ.
При локализации рабдомиосаркомы в клетчатке средостения возможно развитие дыхательной недостаточности, обусловленное уменьшением объема легких. При поражении ЛОР-органов могут возникать дисфагия, синуситы, кровотечения и односторонние выделения из носовых ходов, односторонние отиты и периферический паралич лицевого нерва. При рабдомиосаркомах орбиты возможны косоглазие, птоз и ухудшение зрения. При расположении новообразования в малом тазу возникают запоры и нарушения мочеиспускания.
При опухолях простаты и мочевыводящих путей могут наблюдаться макрогематурия и задержка мочи. Рабдомиосаркомы женских половых органов провоцируют маточные и влагалищные кровотечения. Рабдомиосаркома может давать метастазы в регионарные лимфатические узлы и отдаленные органы. Обычно поражаются кости и легкие. Редко выявляется метастазирование в почки, печень, поджелудочную железу, мозг, мозговые оболочки и сердце.
Диагностика рабдомиосаркомы
Диагноз устанавливается с учетом анамнеза, клинических проявлений, данных лабораторных и инструментальных исследований. При рабдомиосаркомах в области скелетных мышц выполняют МРТ пораженной области. При опухолях ЛОР-органов осуществляют риноскопию, фарингоскопию или отоскопию, при поражении орбиты – осмотр структур глаза. Больных с рабдомиосаркомами ретроперитонеальной локализации направляют на УЗИ брюшной полости и забрюшинного пространства, пациентов с новообразованиями в области малого таза – на УЗИ малого таза.
При рабдомиосаркомах средостения назначают рентгенографию грудной клетки, при опухолях мочевыводящей системы – нефросцинтиграфию, УЗИ почек и УЗИ мочевого пузыря. При подозрении на метастазы в регионарные лимфоузлы проводят УЗИ лимфатических узлов, при подозрении на отдаленное метастазирование в кости и легкие – сцинтиграфию костей скелета, прицельную рентгенографию подозрительного сегмента конечности и рентгенографию грудной клетки.
Лечение и прогноз рабдомиосаркомы
Лечение комплексное, включает в себя лучевую терапию, химиотерапию и радикальное хирургическое вмешательство. При рабдомиосаркомах конечностей осуществляют органосохраняющие операции, при вовлечении кости показана ампутация. При локальных опухолях мочевого пузыря выполняют резекцию, при тотальном поражении органа проводят экстирпацию с последующим формированием пути оттока мочи. При рабдомиосаркомах матки осуществляют гистерэктомию, при новообразованиях во влагалище – удаление влагалища.
Радикальное иссечение рабдомиосарком носоглотки может вызывать существенные затруднения. При невозможности полного удаления операция не показана, больным назначают химиолучевую терапию. Одиночные метастазы в легких при отсутствии вторичных очагов других локализаций удаляют хирургическим путем. При метастазах в кости оперативное вмешательство не проводят из-за неблагоприятного прогноза. При рабдомиосаркомах 4 группы осуществляют интенсивную химиотерапию с последующей пересадкой костного мозга.
Прогноз при рабдомиосаркоме определяется типом, локализацией, размером и распространенностью новообразования, а также возрастом пациента. Самое благоприятное течение характерно для эмбриональных рабдомиосарком. Пятилетняя выживаемость при таких поражениях на 10-20% выше, чем при других типах опухоли. Благоприятными локализациями считаются женские половые органы, поверхностные слои тканей головы и шеи. К числу неблагоприятных локализаций рабдомиосаркомы относят глубокие слои тканей головы и шеи, туловище, конечности, мочевыводящие пути, грудную и брюшную полость. У детей до 7 лет прогноз лучше, чем у пациентов старшего возраста. Средняя пятилетняя выживаемость при опухолях первой клинической группы составляет 80%, второй – 65%, третьей – 40%. Большинство больных рабдомиосаркомой четвертой клинической группы не доживают до пятилетнего срока с момента постановки диагноза.
Лечение рабдомиосаркомы в Израиле: как инновации спасают жизни

Рабдомиосаркома – разновидность злокачественной опухоли, которая развивается из поперечно-полосатых мышц. При мышечные клетки начинают бесконтрольно размножаться и терять свои основные фенотипические показатели. Злокачественные клетки сильно похожи на рабдомиобласты. Это тип клеток, из которых у эмбриона развиваются мышцы.
Точная причина развития рабдомиосаркомы неизвестна. При этом, согласно статистическим данным, более 70% всех больных – это дети младше 10 лет. У мальчиков рабдомиосаркома встречается чаще, чем у девочек.
Всего выделяют два вида данной онкопатологии – плеоморфная и эмбриональная. Первая возникает у людей зрелого возраста, а эмбриональная – у детей и молодых людей. В свою очередь, эмбриональная рабдомиосаркома бывает альвеолярной и кистевидной.
К симптомам заболевания относятся:
- Появление опухолевого новообразования над поверхностью кожных покровов.
- Болезненное ощущение в зоне опухоли.
- Выпячивание глаза и расстройство зрения (если рабдомиосаркома располагается в области глаз).
- Заложенность носа и расстройства слуха (если опухоль располагается в соответствующих областях).
- Гематурия (появление крови в моче), если опухоль располагается в мочеполовой системе.
- Боли и расстройства пищеварительного тракта (если опухоль располагается в органах ЖКТ).
- Другие симптомы.
Как и для большинства других видов рака, для рабдомиосаркомы также характерны такие общие симптомы как увеличение лимфатических узлов, потеря массы тела и заметное ухудшение аппетита.
Лучшие клиники Израиля
Клиника Ихилов (Сураски)
Медцентр Шиба
Клиника Рамбам

Медицинский центр Бней-Цион (больница Ротшильд)
Клиника Герцлия
Клиника Хадасса
Клиника Ассута

Больница Шаарей Цедек
Методы лечения рабдомиосаркомы в Израиле
В израильских клиниках, как правило, прибегают к комбинированному лечению рабдомиосарком. В зависимости от вида опухоли, ее размеров и локализации, применяется один или несколько нижеследующих метода:
- Хирургия. Хирурический метод лечения рабдомиосаркомы – наиболее эффективный, позволяющий избавиться от опухоли. При этом варианты хирургического вмешательства могут быть различными в зависимости от локализации и размеров новообразования. В большинстве случаев израильские специалисты обходятся малоинвазивными вмешательствами, однако иногда приходится проводить открытые операции для эффективного удаления новообразования. Примечательно, что во многих клиниках Израиля используется и роботизированная установка «Да Винчи», позволяющей проводить вмешательства максимально точно (до миллиметра) и без обильных кровопотерь.
- Химиотерапия. Злокачественные клетки рабдомиосаркомы достаточно чувствительны к химиопрепаратам, а поэтому данный метод лечения почти всегда используется в лечении. Как правило, химиотерапия применяется как до, так и после операции. Перед хирургией химиотерапевтические препараты необходимы, чтобы добиться уменьшения размеров опухоли. После операции химиотерапия применяется для устранения остаточного количества злокачественных клеток, которые все еще могут оставаться в организме после удаления основного опухолевого очага. Для химиотерапевтического лечения рабдомиосаркомы применяются различные комбинации препаратов. Это цитостатические антибиотики, аликлирующие противораковые препараты, препараты платины, а также химиотерапевтические препараты из группы антрациклинов.
- Лучевая терапия. Как правило, лучевая терапия в данном случае проводится после нескольких курсов химиотерапии. Происходит это примерно на 12 неделе лечения. Однако в некоторых случаях врачи могут принять решение начать лучевую терапию вместе с химиотерапией. В зависимости от количества новообразований, локализации и размеров, врачи проводят 20-28 сеансов лучевой терапии рабдомиосаркомы. Чаще всего при рабдомиосаркомах используется дистанционная лучевая терапия, однако в некоторых случаях проводится и контактная радиотерапия. В последнем случае в опухоль имплантируются миниатюрные капсулы, обладающие радиоактивностью. Таким образом, опухоль облучается изнутри. Спустя некоторое время капсулы извлекают.
- Иммунотерапия. Это новаторский метод лечения раковых опухолей, который стал применяться в последние годы. Суть лечения сводится к активизации иммунной системы пациента против раковых клеток. Некоторые препараты для иммунотерапии рака угнетают активность некоторых белков-регуляторов, которые не дают возможности иммунным клеткам распознавать раковые клетки. Если такой белок отключить, то Т-лейкоциты начинают атаковать раковые клетки. За открытие таких белков-тормозов иммунной системы в 2018 году была присуждена Нобелевская премия по медицине и физиологии, поскольку открытие данного механизма послужило базисом для иммунотерапии.
- Таргетная терапия. Еще один вариант инновационного лечения раковых опухолей, при котором используются препараты, прицельно действующие на определенные молекулярные мишени, которые вовлечены в процесс роста злокачественной опухоли. Подавление активности этих молекул неминуемо приведет к остановке роста новообразования и его регрессу.
Диагностика рабдомиосаркомы в Израиле
Диагностика рабдомиосаркомы проходит в течение 3-4 суток. За это время врачи проводят все необходимые исследования и назначают схему лечения.
День первый – консультация

В первый день проходит консультация лечащего врача, который внимательно опрашивает и осматривает больного. Израильский онколог изучает всю медицинскую документацию, а также отправляет на ревизию предоставленные пациентом материалы предыдущих исследований (если таковые имеются).
Примечательно, то пройти консультацию у израильского врача можно и заочно. Так, если вам поставили диагноз у вас на родине, но вы желаете проконсультироваться с квалифицированным иностранным врачом и узнать альтернативную точку зрения, то можете заказать услугу «второе мнение». Для этого вы присылаете все медицинские документы, касающиеся заболевания, и после нескольких дней израильский врач связывается с вами по скайпу и оглашает свое заключение. Если в дальнейшем вы примите решение лечиться или обследоваться в соответствующей израильской клинике, то первая очная консультация врача в таком случае будет бесплатной.
День второй – диагностические процедуры
- Лабораторные анализы крови.
- Рентгенологические исследования.
- Компьютерная томография (КТ).
- Магнитно-резонансная томография (МРТ).
- Специфические исследования в зависимости от локализации опухоли (например, УЗИ глазницы, остеосцинтиграфия, люмбальная пункция и другие).
- Биопсия и последующее гистопатологическое исследования взятого образца опухолевой ткани.
День третий – заключение врачей
На третий день собирается экспертная группа врачей, которая внимательно изучает полученную информацию, устанавливает диагноз и определяется со схемой лечения больного.
Лечение рабдомиосаркомы в Израиле: цены
Подробнее о ценах вы можете узнать у наших консультантов, с которыми можете связаться прямо на сайте. Вы также можете прочитать отклики про лечение рабдомиосаркомы в Израиле (отзывы иностранных пациентов, которые прошли лечение в израильских клиниках и решили поделиться своей историей на сайте Ассоциации Клиник Израиля).
Читайте также:
